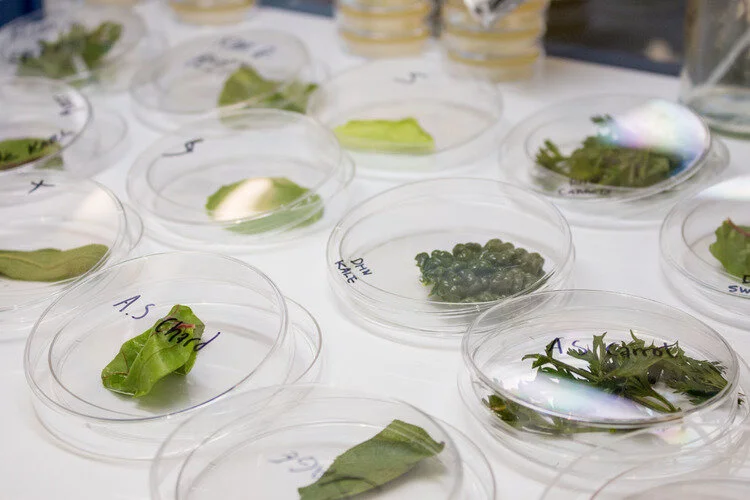

BDC Alumni Open Call for Biodesigned
BDC Alumni Open Call for Biodesigned
We’re seeking submissions from BDC alumni for an open call to Biodesigned, our online magazine. We want to hear from you!
Here’s the prompt:
The year is 2071: The ways we eat have changed. What does the future of food taste like? How have climate change, biotech, geopolitics, and other factors transformed the way people cultivate, prepare, and consume food?
We welcome you to send videos, audio clips, illustrations, animations, photography, or text as responses to the prompt.
Image: Tumo BDC SVA 2016